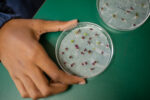
Fast plants in a petri dish

Workshop Resources

Earth & Space Science
6-8
Middle School
In this workshop, teachers will be introduced to the four elements of the anchoring phenomenon routine from OpenSciEd for Middle School. Teachers will experience firsthand the anchoring phenomena of Mount Everest and how to motivate students to explore and explain real-world phenomena. During the workshop teachers develop strategies for creating a driving question board and encouraging equitable classroom discourse.
Explore More Workshop Resources
Get Free Resources Delivered to Your Inbox!
About The Author
Carolina Staff
Carolina is teamed with teachers and continually provides valuable resources–articles, activities, and how-to videos–to help teachers in their classroom.